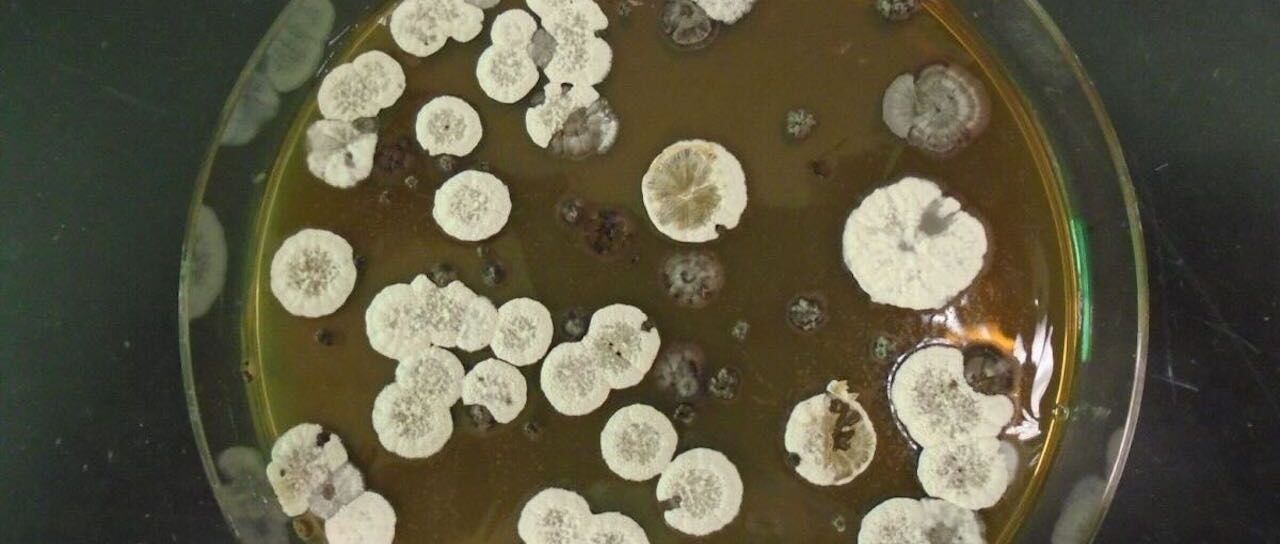
Todas las noticias de coches en un solo portal: Pruebas, fotos, vídeos, informes...

Este biocombustible producido por bacterias tiene mayor densidad de energía que el combustible para aviones
Los combustibles fósiles son maravillosos por la energía que contienen, pero no se puede negar su impacto en el planeta. Ahora, los investigadores de Berkeley Lab han logrado que unas bacterias produzcan directamente un nuevo biocombustible con una densidad de energía significativamente mayor que el combustible para aviones.
Estas nuevas moléculas candidatas a convertirse en un futuro combustible se conocen como ésteres metílicos de ácidos grasos policiclopropanados (POP-FAME), y están compuestos por siete juegos de anillos de ciclopropano. Se trata de anillos de tres átomos de carbono unidos en formas triangulares, lo que obliga a los enlaces a formar un ángulo de 60 grados. Las tensiones de ese ángulo agudo tienen un alto potencial de energía, que se libera durante la combustión.
Los investigadores encontraron estas bacterias naturales productoras de ciclopropano en una familia llamada Streptomyces y luego copiaron los genes asociados en otras bacterias que son más aptas para el laboratorio. El resultado final fueron moléculas POP-FAME que el equipo denominó fuelimicinas, que solo requieren un paso adicional de procesamiento químico para convertirlas en combustible listo para quemar.
Con posterioridad, los científicos de Sandia National Labs realizaron simulaciones por computadora de los combustibles resultantes para estimar sus propiedades en comparación con los combustibles convencionales. Este análisis sugirió que los nuevos combustibles serían seguros y estables a temperatura ambiente y tendrían una densidad de energía de más de 50 megajulios por litro. Eso es mucho. La densidad de energía de la gasolina es de alrededor de 32 MJ/L, mientras que los combustibles comunes para aviones y cohetes superan los 35 MJ/L.

Esta mayor densidad de energía conseguiría que los vehículos llegasen más lejos con un solo tanque de combustible, o reducir la cantidad de combustible necesario para el lanzamiento de cohetes, ahorrando espacio y peso para la carga. Además, la producción de combustibles a partir de bacterias reduce su impacto ambiental.
“Esta investigación proporciona una ruta limpia hacia combustibles de alta densidad energética que, antes de este trabajo, solo podían producirse a partir del petróleo mediante un proceso de síntesis altamente tóxico”, asegura Jay Keasling, líder del proyecto. “Como estos combustibles se producirían a partir de bacterias alimentadas con materia vegetal, que procede de dióxido de carbono extraído de la atmósfera, quemarlos en los motores reducirá la cantidad de gases de efecto invernadero agregados en relación con cualquier combustible generado a partir del petróleo”.
Estos biocombustibles todavía no están listos para su uso. El equipo necesita encontrar formas de hacer cantidades más grandes para que probarlos en motores. También planean investigar formas de hacer moléculas de diferentes longitudes para diferentes propósitos. Eric Sundstrom, autor del estudio, indica que “los combustibles de cadena más larga serían sólidos, muy adecuados para ciertas aplicaciones de combustible para cohetes, las cadenas más cortas podrían ser mejores para el combustible para aviones, y también podría haber una molécula alternativa al diésel”.
Fuente: Lawrence Berkeley National Laboratory
Más información: Joule
Noticias relacionadas

Lo viste en Matrix: los científicos idean una batería de azúcar y vitaminas inspirada en el cuerpo humano

La recarga en marcha se hace realidad: pruebas en carretera demuestran la eficacia de la carga inalámbrica dinámica

El motor axial de YASA reescribe de nuevo los límites de la potencia eléctrica

El autobús escolar que da electricidad a la ciudad ya funciona en Estados Unidos
¿Te ha gustado esta prueba?
Subscríbete y no te pierdas las últimas novedades cada semana



